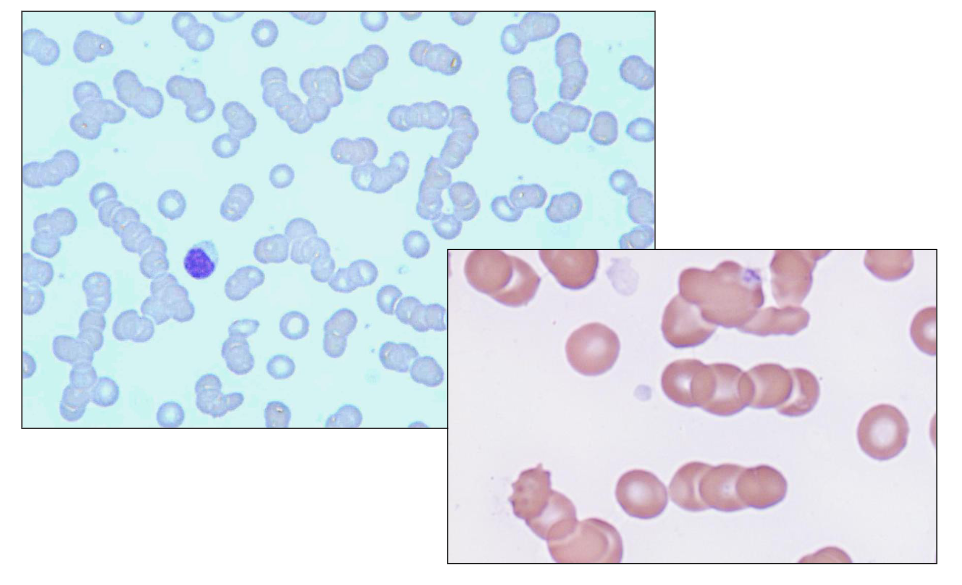
<p>- the paraprotein sticks to red blood cell and when there is paraprotein on the red blood cell they become stickier</p><p>- They stack on top of eachother like a stack of coins.</p><p>- look how in the diagram all the cells stack on top of eachother</p>
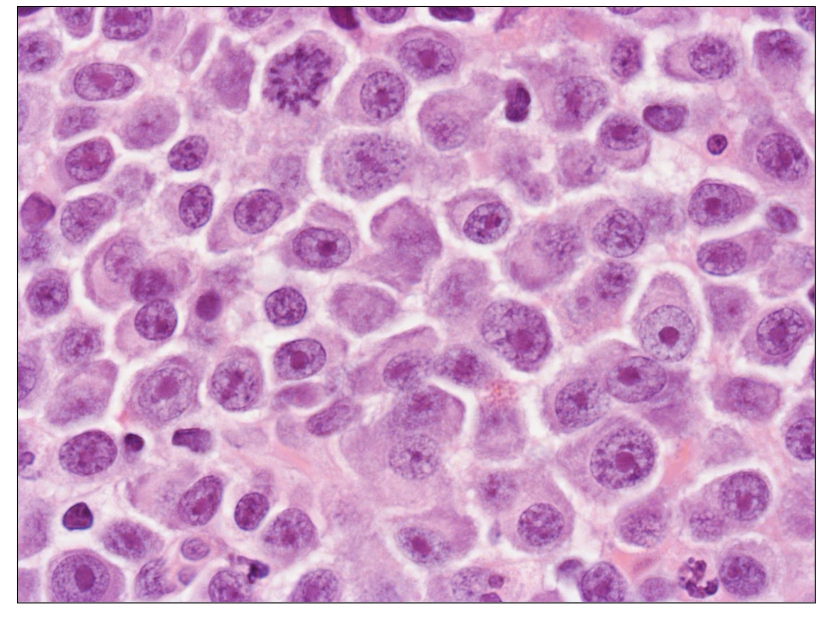
<p>Bone Marrow Trephine</p>

(L14) IMED2002 - Plasma Cell Myeloma
1/29
There's no tags or description
Looks like no tags are added yet.
Name | Mastery | Learn | Test | Matching | Spaced | Call with Kai |
|---|
No analytics yet
Send a link to your students to track their progress
30 Terms

Multiple Myeloma
- Malignant disorder of plasma cells
.
Characterised by:
- Excess (clonal) plasma cells in the bone marrow
- Monoclonal immunoglobulin (paraprotein) in the serum and / or urine
- Bone changes: pain and fractures
.
- 2nd most common "blood cancer"; 50 cases per million population
- Cause is unknown
- Treatable but incurable


What are plasma cells? End stage B-cells
- note how its CD38 and CD138

Multiple Myeloma Info
- Peak age > 60 years
- Clinical problems from organ infiltration by neoplastic plasma cells: especially bone marrow
- Anaemia from marrow infiltration
- Bleeding from platelet dysfunction (Ig coating)
- Calcium loss from bone resorption
.
- Recurrent infections are common:
- Streptococcus; Staphylococcus; E. coli
- Marrow failure and hypo-gammaglobulinaemia
.
- Renal failure

Clinical Features: Symptoms
- Bone pain: lower back is common
- Bone (pathological) fracture without obvious injury: osteolytic bone lesions from increased osteoclastic and decreased osteoblastic activity
- Infections: infection difficult to overcome(pneumonia is common presenting feature)
- Kidney problems; renal failure
- Epistaxis (heavy nosebleeds) or easy bruising
- Drowsiness; confusion (high serum protein)
- Symptoms of bone marrow failure: anaemia


Cause of Clinical Manifestations
Plasma cell proliferation:
- Pancytopenia, anaemia
- Bone damage, lytic lesions
- Constitutional symptoms
- Anorexia
- Hypercalcemia
.
Monoclonal protein produced by plasma cells:
- Renal failure
- Hyperviscosity
- Neurologic symptoms
.
Immunodeficiency
- Infections: due to low levels of normal immunoglobulins


Monoclonal Protein in Myeloma
- Immunoglobulins are proteins normally made by plasma cells
- Single type produced by one clone of plasma cells
- Same Ig produced by all myeloma cells (monoclonal) = "paraprotein" or "M protein"
- Intact Ig (heavy and light) chains or light chain only
- Can be measured at diagnosis in blood (and urine)
- Level can be tracked for disease response and relapse
.
- the protein (paraprotein) deposits on the kidney cells, the glomerula and the deposition

Laboratory Features of Myeloma
- Anaemia, often neutropenia and thrombocytopenia
- Blood film: rouleaux; occ. circulating plasma cells
- ESR elevated
.
Serum:
- Paraprotein: monoclonal Ig: IgG > IgA > other Ig
- Reduced normal Ig; free serum light chains - Other: Βeta-2-macroglobulin; calcium
.
- Bone marrow: plasma cell infiltrate (>10%)
- Urine: Bence-Jones protein (free light chains of Ig)
- Radiological imaging
.
- no heavy chains in Bence-Jones because they dont pass through the glomerular filtrate part
.
- ESR is basically a test where we see how long it takes for the red blood cell to settle down and the time it takes is the results that it is
- anyone that carries more protein in blood, there is more for that red blood cell to pass through to then settle down
.
- difference between serum and plasma is coagulation facors

Blood Film: Rouleaux
- the paraprotein sticks to red blood cell and when there is paraprotein on the red blood cell they become stickier
- They stack on top of eachother like a stack of coins.
- look how in the diagram all the cells stack on top of eachother
Laboratory Features: Immunoglobulins
Immunoglobulins (quantitative):
- Total plasma immunoglobulins (Ig): elevated
- Reduced levels of normal immunoglobulins
- Overall increase due to paraprotein
- Serum free light chains and kappa/lambda ratio (light chains not part of intact Ig)
.
Serum Protein Electrophoresis:
- Identifies and quantifies monoclonal proteins
- Monoclonal protein in the gamma region: paraprotein or the "M" spike

Protein EPG and Immunofixation
LEFT DIAGRAM: Protein Electrophoresis
- Separates proteins in blood based on electrical charge
- Detects "M" proteins
.
RIGHT DIAGRAM:
- Detects and quantifies Ig
- Identification of paraprotein using antibodies
.
- we see an M spike which indicates paraproteins in blood
- the right diagram shows that there is presence of IgA Kappa Paraprotein


Plasma Cell Diagram Bone Marrow Analysis
- this is a plasma cell (bundle)
- eccentrically placed nucleus and nucleus is quite matured
- chromatin is clumped
- we have basophillic staining

Bone Marrow Trephine
DIAGRAM ON SLIDE 13


Flow Cytometry
- Antigens can be used to identify plasma cells and differentiate "normal" from "neoplastic"
.
PLASMA CELLS DEFINED BY CD38/CD138 DUAL EXPRESSION is diagram on LEFT
.
RIGHT IMAGE
NORMAL PLASMA CELLS: CD19 POSITIVE
NEOPLASTIC PLASMA CELLS: CD19 NEGATIVE


Clinical Case
- we can see mild anaemia
- leucopenia
- thrombocytopenia
- ESR is high (normal range is no more than 25)


Clinical Case: Protein Studies
- Total Immunoglobulins (Ig) is 38, but IgG only makes up 6.2
- high Paraprotein means that the body is being distracted from producing normal

Bone Imaging Methods
CT Skeletal survey:
- CT of skull, long bones & axial skeleton
- Detects "lytic lesions" (local loss of bone)
- Size of local lesion
.
Magnetic Resonance Imaging:
- More sensitive than skeletal survey (especially for vertebral disease)
.
Radionuclide imaging (bone scan):
- Unable to detect lytic lesions ("cold spot")
- No new bone formation ("hot spot")

Skeletal Survey: Lytic Bone Lesions
Skeletal survey includes:
- Lateral skull
- Frontal chest film
- Cervical-thoracolumbar spine
- Shoulders
- Pelvis, femur
.
Majority of lesions are sharply defined and lytic

Complication: Renal Failure in Myeloma
- Renal failure is common
- Large amount of protein cleared in the urine
- Lambda light chains (Bence Jones protein) accumulate in kidney; toxic to renal epithelium
- Hypercalcemia
- Monitoring serum calcium and renal function is essential

Definition of Myeloma (IMWG 2014)
- this slide shows that cancer is not an event, but a series fo events
- the key things is the number of plasma cells. Its meant to be less then 5%
- anything more then 10% is Multiple Myeloma


Natural History of Myeloma
- active myeloma is symptomatic

Symptomatic Myeloma
1. Clonal plasma cells in bone marrow
2. Monoclonal protein (paraprotein)
3. Evidence of end-organ damage 2o to the plasma cells (CRAB) or myeloma-related end-organ damage
- HyperCalcaemia
- Renal insufficiency
- Anaemia (Hb <100 g/l)
- Lytic Bone lesions or osteoporosis
.
4. SLiM criteria: >60% plasma cells; k/l light chain ratio >100; more than one MRI bone lesion
Myeloma Management
- Median survival approximately 5 - 7 years
.
Smouldering myeloma:
- Stable with normal blood counts and renal function and no bone complications (no CRAB features)
- "Watch and wait"
.
Symptomatic myeloma:
- One or more CRAB features - Chemotherapy is indicated - Treatment determine by age and performance status - "Plateau phase" or stable disease reached in most: near normal blood count; <5% plasma cells. 1-3 years
Myeloma Management (Therapy, Most patients relapse)
Therapy:
- Alkylating agents: remission in 50-70%
- Bisphosphonates to inhibit bone resorption
- Chemotherapy: melphalan, vincristine, cyclophosphamide
- Immunomodulators: thalidomide, lenalidomide, pomalidomide
- Proteasome inhibitors: bortezomib, carfilzomib
- Monoclonal antibodies: daratumumab
- CAR-T cells
- Bispecific antibodies: teclistamab, elranatamab
- Young: autologous stem cell (marrow) transplantation
.
Most patients relapse:
- Re-induction chemotherapy; radiotherapy for bone lesions
- Causes of death: renal failure, infections and haemorrhage

The Principle of Autologous Transplant
- autologous means own (patients own transplant)


Prognosis: 5 year survival
DIAGRAM ON SLIDE 26


The Principle of CAR-T cell Therapy
- first we collcet blood from patient
- next, we isolate T cell from the blood
- by taking out T cell we can enrich them, activate them and from that point, transduce an extra gene product into the T cell
- So T cell has its own gene, byt we are introducing by manipulating the genetic product into the T cell in which we trick the T cell to say "this is part of yoyr genome, produce the protein"
- and the protein is therefore expressed on the surfcae of the T cell (we call it a chimeric antigen receptor)
- it could be anything you want to target (theoretically)
- in myeloma cell, we target whatever is on the myeloma
- theres on ecalled BCMA which is a protein tahts expressed on the myeloma cell


The Principle of Bispecific Therapy
- we have something called bispecific, same concept as before
- we want to enhance the T cell to fight the cancer cell
- T cell express CD3
- Myeloma cell as he mentioned myeloma cell express a protein called BCMA
- this is bi-specific
- BCMA links to CD3
- brings the T cell closer to the BCMA, expressing myeloma cell
- it enhances the myeloma killing as a result

Prognostic Markers: Biochemistry
Biochemistry
- Paraprotein level
• β2 microglobulin
- Normal <0.2 mg/dL
- Stage 1: < 3.5 mg/L
- Stage 2: 3.5-5.5 mg/L
- Stage 3: > 5.5 mg/L
.
Serum free light chains
- Measures free fraction of light chain (not bound to heavy chain of Ig)
- Used for disease monitoring and prognostic prediction
- Ratio free kappa: lambda

Prognosis of Myeloma: Chromosomes
- high risk is deletion of 17p, translocation of 14 and 16 as well as translocation of 14 and 20 (lot involve 14 because 14 is where heavy chain is produced)


Myeloma: Learning Outcomes
DIAGRAM ON SLIDE 31
